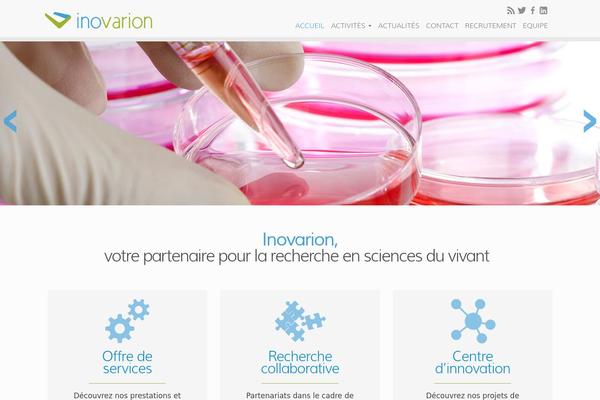
inovarion.com site used Adveris

Chart of Usage Adveris theme
Chart of usage and recent updates of Adveris theme. Active site count was updated in April, 2024
How has the number of active sites using Adveris changed?
We conducted an analysis of Adveris wp theme alongside other popular WordPress themes to compile an independent research report on recent usage statistics. This study covers the period from May, 2023 - April, 2024
-
From May to June, the number of websites using the Adveris WordPress theme increased by 0 , representing a 0.0% rise.
From June to July, Adveris website count was a further increased of 0 websites, a 0.0 % growth.
From July to August, there was a modest increase of 0 websites, or 0.0% .
From August to September, there was a rebound with an increase of 0 websites, or 0.0% .
From September to October, the number grew by 0 websites built with Adveris, indicating a 0.0% increase.
Yet, from October to November, the number of websites rose by 0, marking a 0.0% increase.
From November to December, the number grew by 0 websites, indicating a 0.0% increase.
However, from December to January, there was an increase of 0 websites, representing a growth of 0.0%.
From January to February, the number of websites increased by 0, a growth of 0.0% .
From February to March, there was a slight increase of 1 websites launched by Adveris, amounting to a 0.0% growth.
From March to April, the number rebounded with an increase of 0 websites, a 0.00% growth.
From April to May. 2024, the number grew by 0 websites, indicating a 0.00% increase.
- Get a FREE Domain Name with Any Hosting Plan | Domain.com